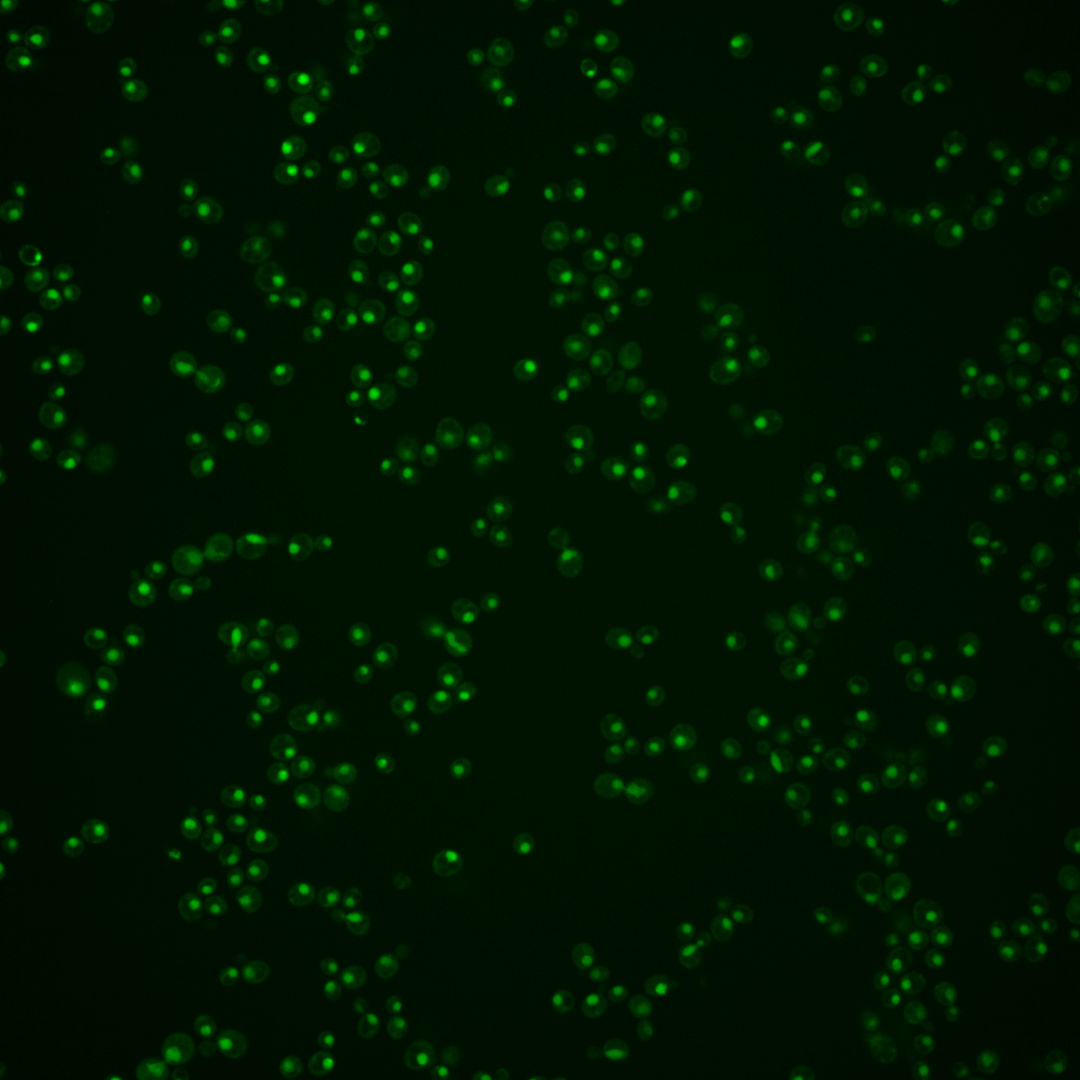
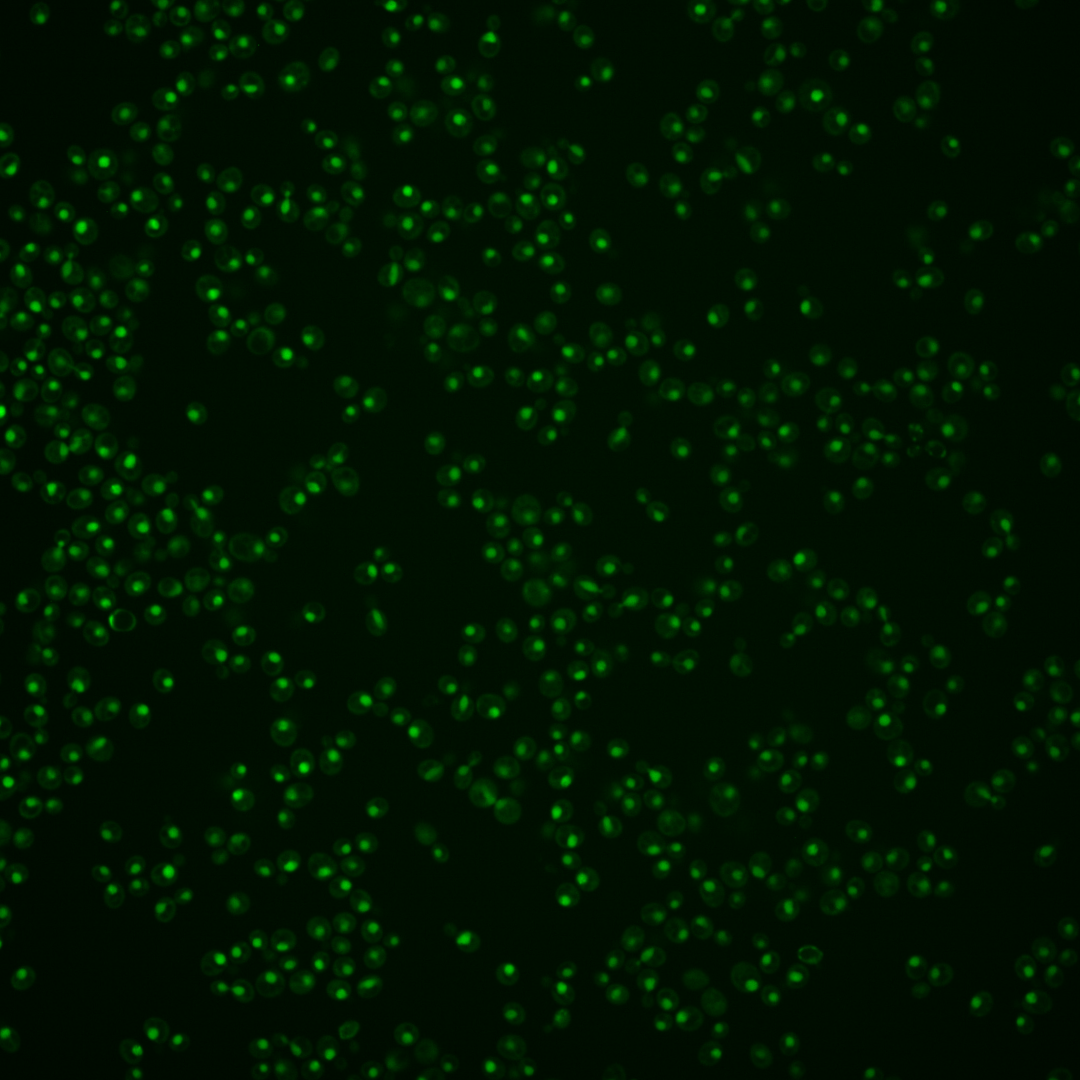
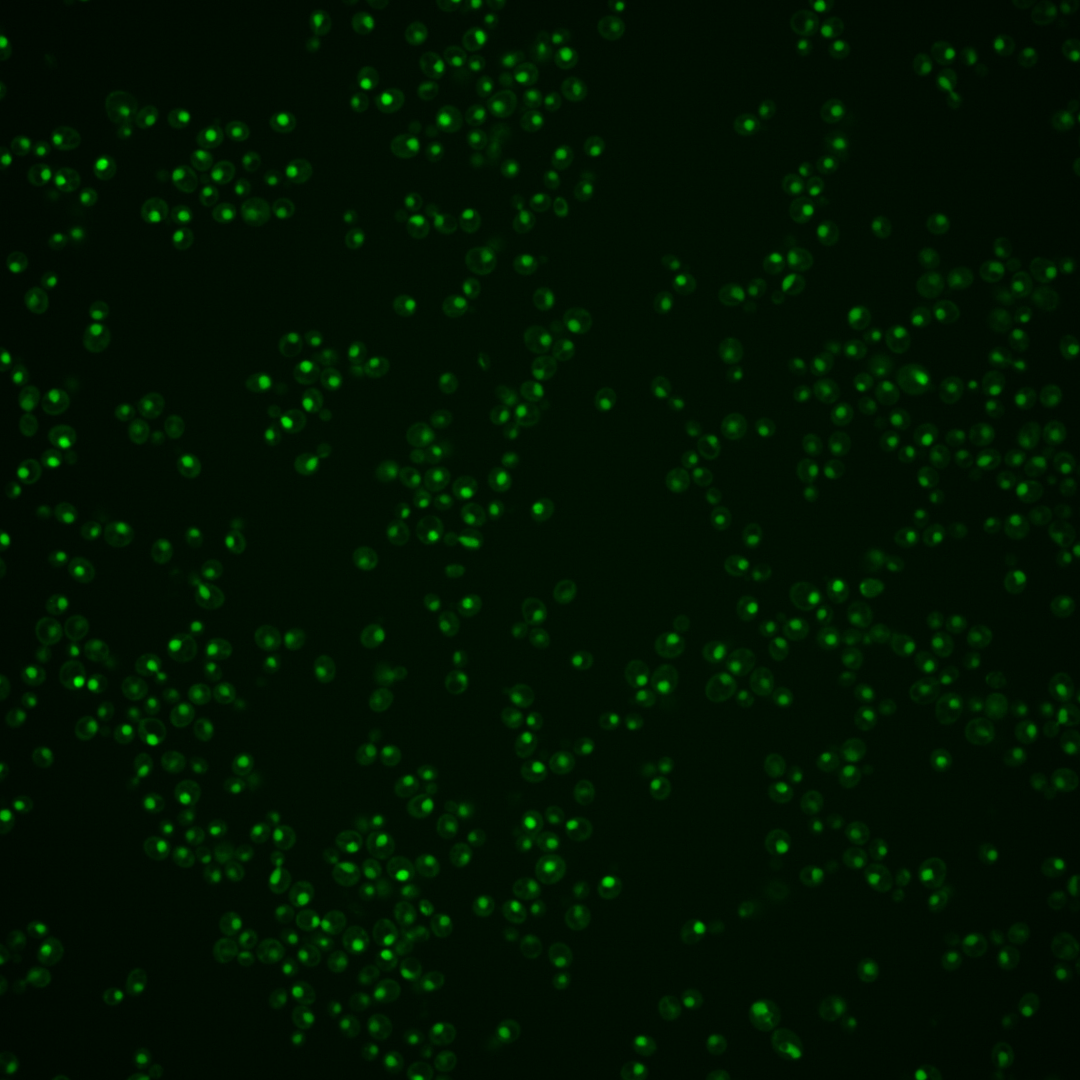

| Standard name | |
|---|---|
| Human Ortholog | |
| Description | Subunit of heteropentameric Replication factor C (RF-C); which is a DNA binding protein and ATPase that acts as a clamp loader of the proliferating cell nuclear antigen (PCNA) processivity factor for DNA polymerases delta and epsilon; relocalizes to the cytosol in response to hypoxia |
Micrographs




















































































Sub-cellular Localization
Yeast GFP Assignment
Protein Abundance
Localization Change
External localization resources
| ensLOC | DeepLoc | |||||||||||||||||||||||
|---|---|---|---|---|---|---|---|---|---|---|---|---|---|---|---|---|---|---|---|---|---|---|---|---|
| Localization | WT1 | WT2 | WT3 | RAP60 | RAP140 | RAP220 | RAP300 | RAP380 | RAP460 | RAP540 | RAP620 | RAP700 | HU80 | HU120 | HU160 | rpd3Δ_1 | rpd3Δ_2 | rpd3Δ_3 | WT1 | WT2 | WT3 | AF100 | AF140 | AF180 |
| Cortical Patches | 0 | 0 | 0 | 0 | 0 | 0 | 0 | 0 | 0 | 0 | 0 | 0 | 0 | 0 | 0 | 0 | 0 | 0 | 0 | 0 | 0 | 0 | 1 | 0 |
| Bud | 0 | 0 | 0 | 1 | 0 | 1 | 6 | 6 | 2 | 1 | 4 | 2 | 1 | 0 | 0 | 1 | 0 | 1 | 3 | 1 | 0 | 2 | 5 | 2 |
| Bud Neck | 0 | 0 | 0 | 0 | 1 | 0 | 0 | 2 | 0 | 0 | 0 | 0 | 0 | 1 | 0 | 0 | 0 | 0 | 0 | 0 | 0 | 0 | 0 | 0 |
| Bud Site | 1 | 0 | 0 | 0 | 2 | 10 | 2 | 8 | 9 | 15 | 10 | 10 | 0 | 0 | 0 | 0 | 0 | 0 | – | – | – | – | – | – |
| Cell Periphery | 0 | 0 | 0 | 0 | 0 | 0 | 0 | 0 | 0 | 0 | 0 | 0 | 0 | 0 | 0 | 0 | 0 | 0 | 0 | 0 | 0 | 0 | 0 | 0 |
| Cytoplasm | 3 | 5 | 5 | 7 | 13 | 24 | 18 | 13 | 14 | 13 | 15 | 9 | 12 | 38 | 45 | 21 | 22 | 25 | 0 | 1 | 0 | 4 | 1 | 1 |
| Endoplasmic Reticulum | 0 | 0 | 0 | 0 | 1 | 0 | 0 | 0 | 1 | 0 | 0 | 0 | 0 | 0 | 1 | 10 | 0 | 4 | 0 | 0 | 0 | 0 | 0 | 1 |
| Endosome | 1 | 0 | 2 | 0 | 0 | 0 | 0 | 0 | 0 | 0 | 0 | 0 | 0 | 0 | 3 | 4 | 1 | 1 | 0 | 2 | 1 | 0 | 1 | 3 |
| Golgi | 0 | 0 | 0 | 0 | 0 | 0 | 0 | 0 | 0 | 0 | 0 | 0 | 0 | 0 | 0 | 0 | 3 | 2 | 0 | 1 | 0 | 0 | 1 | 0 |
| Mitochondria | 20 | 4 | 3 | 8 | 2 | 47 | 92 | 75 | 138 | 105 | 111 | 55 | 2 | 0 | 0 | 7 | 4 | 9 | 2 | 1 | 2 | 2 | 3 | 5 |
| Nucleus | 334 | 230 | 163 | 189 | 266 | 294 | 307 | 320 | 280 | 296 | 165 | 174 | 131 | 154 | 134 | 194 | 159 | 194 | 327 | 229 | 158 | 121 | 150 | 138 |
| Nuclear Periphery | 8 | 1 | 0 | 1 | 0 | 4 | 2 | 1 | 1 | 3 | 4 | 0 | 1 | 1 | 3 | 2 | 3 | 2 | 0 | 0 | 0 | 1 | 1 | 8 |
| Nucleolus | 11 | 1 | 4 | 0 | 3 | 8 | 21 | 13 | 34 | 28 | 20 | 24 | 0 | 3 | 10 | 5 | 3 | 2 | 2 | 3 | 1 | 10 | 12 | 12 |
| Peroxisomes | 0 | 0 | 0 | 0 | 0 | 0 | 0 | 0 | 0 | 0 | 0 | 0 | 0 | 0 | 0 | 1 | 0 | 0 | 0 | 0 | 0 | 0 | 0 | 0 |
| SpindlePole | 0 | 0 | 2 | 1 | 1 | 1 | 0 | 3 | 0 | 3 | 1 | 1 | 1 | 1 | 1 | 3 | 0 | 0 | 2 | 1 | 0 | 0 | 2 | 1 |
| Vac/Vac Membrane | 7 | 6 | 1 | 2 | 1 | 2 | 3 | 3 | 6 | 6 | 1 | 4 | 1 | 3 | 16 | 19 | 9 | 8 | 10 | 8 | 4 | 18 | 37 | 37 |
| Unique Cell Count | 350 | 245 | 173 | 202 | 282 | 333 | 365 | 378 | 341 | 356 | 225 | 214 | 146 | 199 | 201 | 242 | 195 | 231 | 350 | 253 | 171 | 167 | 225 | 215 |
| Labelled Cell Count | 385 | 247 | 180 | 209 | 290 | 391 | 451 | 444 | 485 | 470 | 331 | 279 | 149 | 201 | 213 | 267 | 204 | 248 | 350 | 253 | 171 | 167 | 225 | 215 |
Yeast GFP Assignment
Protein Abundance
| Screen | WT1 | WT2 | WT3 | RAP60 | RAP140 | RAP220 | RAP300 | RAP380 | RAP460 | RAP540 | RAP620 | RAP700 | HU80 | HU120 | HU160 | rpd3Δ_1 | rpd3Δ_2 | rpd3Δ_3 | AF100 | AF140 | AF180 |
|---|---|---|---|---|---|---|---|---|---|---|---|---|---|---|---|---|---|---|---|---|---|
| Mean Cell GFP Intensity (1e-4) | 6.6 | 9.2 | 7.2 | 7.1 | 7.2 | 5.5 | 5.1 | 5.5 | 5.0 | 5.5 | 4.8 | 5.1 | 7.9 | 8.4 | 9.0 | 8.6 | 9.4 | 8.9 | 8.2 | 8.4 | 8.6 |
| Std Deviation (1e-4) | 1.5 | 2.0 | 1.6 | 1.8 | 2.0 | 1.8 | 1.5 | 1.4 | 1.7 | 1.9 | 1.9 | 1.5 | 2.0 | 3.2 | 4.7 | 2.4 | 2.4 | 2.6 | 2.5 | 2.9 | 2.7 |
| Intensity Change (Log2) | – | – | – | -0.03 | -0.01 | -0.38 | -0.49 | -0.39 | -0.53 | -0.4 | -0.6 | -0.52 | 0.13 | 0.22 | 0.32 | 0.25 | 0.37 | 0.3 | 0.17 | 0.21 | 0.25 |
Localization Change
| Localization | RAP60 | RAP140 | RAP220 | RAP300 | RAP380 | RAP460 | RAP540 | RAP620 | RAP700 | HU80 | HU120 | HU160 | rpd3Δ_1 | rpd3Δ_2 | rpd3Δ_3 |
|---|---|---|---|---|---|---|---|---|---|---|---|---|---|---|---|
| Cortical Patches | 0 | 0 | 0 | 0 | 0 | 0 | 0 | 0 | 0 | 0 | 0 | 0 | 0 | 0 | 0 |
| Bud | 0 | 0 | 0 | 0 | 0 | 0 | 0 | 0 | 0 | 0 | 0 | 0 | 0 | 0 | 0 |
| Bud Neck | 0 | 0 | 0 | 0 | 0 | 0 | 0 | 0 | 0 | 0 | 0 | 0 | 0 | 0 | 0 |
| Bud Site | 0 | 0 | 0 | 0 | 0 | 0 | 0 | 0 | 0 | 0 | 0 | 0 | 0 | 0 | 0 |
| Cell Periphery | 0 | 0 | 0 | 0 | 0 | 0 | 0 | 0 | 0 | 0 | 0 | 0 | 0 | 0 | 0 |
| Cytoplasm | 0.3 | 0.9 | 2.0 | 1.1 | 0.3 | 0.7 | 0.5 | 1.7 | 0.7 | 2.1 | 4.9 | 5.5 | 2.4 | 3.1 | 3.0 |
| Endoplasmic Reticulum | 0 | 0 | 0 | 0 | 0 | 0 | 0 | 0 | 0 | 0 | 0 | 0 | 0 | 0 | 0 |
| Endosome | 0 | 0 | 0 | 0 | 0 | 0 | 0 | 0 | 0 | 0 | 0 | 0 | 0 | 0 | 0 |
| Golgi | 0 | 0 | 0 | 0 | 0 | 0 | 0 | 0 | 0 | 0 | 0 | 0 | 0 | 0 | 0 |
| Mitochondria | 1.3 | 0 | 4.4 | 6.7 | 5.7 | 9.3 | 7.4 | 0 | 6.6 | 0 | 0 | 0 | 0 | 0 | 1.3 |
| Nucleus | -0.3 | 0 | -2.1 | -3.3 | -3.2 | -3.8 | -3.5 | -5.4 | -3.8 | -1.5 | -4.6 | -6.6 | -4.1 | -3.7 | -3.2 |
| Nuclear Periphery | 0 | 0 | 0 | 0 | 0 | 0 | 0 | 0 | 0 | 0 | 0 | 0 | 0 | 0 | 0 |
| Nucleolus | 0 | 0 | 0 | 1.8 | 0.7 | 3.1 | 2.5 | 0 | 3.4 | 0 | 0 | 1.4 | 0 | 0 | 0 |
| Peroxisomes | 0 | 0 | 0 | 0 | 0 | 0 | 0 | 0 | 0 | 0 | 0 | 0 | 0 | 0 | 0 |
| SpindlePole | 0 | 0 | 0 | 0 | 0 | 0 | 0 | 0 | 0 | 0 | 0 | 0 | 0 | 0 | 0 |
| Vacuole | 0 | 0 | 0 | 0 | 0 | 0 | 0 | 0 | 0 | 0 | 0 | 3.4 | 3.4 | 0 | 0 |
External localization resources
Images






























Protein Concentration and Protein Localization Data
| R1 | R2 | R3 | ||||||||||||||||
|---|---|---|---|---|---|---|---|---|---|---|---|---|---|---|---|---|---|---|
| G1 Pre-START | G1 Post-START | S/G2 | Metaphase | Anaphase | Telophase | G1 Pre-START | G1 Post-START | S/G2 | Metaphase | Anaphase | Telophase | G1 Pre-START | G1 Post-START | S/G2 | Metaphase | Anaphase | Telophase | |
| Concentration | 2.6987 | 2.6498 | 2.4211 | 2.134 | 1.3778 | 2.3895 | 2.7831 | 3.2077 | 2.812 | 2.0841 | 2.0031 | 2.8217 | 2.9268 | 2.8437 | 2.6049 | 2.0812 | 2.2334 | 2.6183 |
| Actin | 0.0027 | 0 | 0.001 | 0.0065 | 0.0196 | 0.0001 | 0.0059 | 0 | 0.0007 | 0.0002 | 0.0001 | 0.0011 | 0.0182 | 0 | 0.0001 | 0.0024 | 0 | 0 |
| Bud | 0.0002 | 0 | 0.0001 | 0.0007 | 0.0007 | 0.0001 | 0.0002 | 0 | 0.0001 | 0 | 0 | 0 | 0.0002 | 0 | 0.0003 | 0.0001 | 0 | 0 |
| Bud Neck | 0.0016 | 0.0001 | 0.0005 | 0.0008 | 0.0007 | 0.0015 | 0.0044 | 0.0001 | 0.0003 | 0.0002 | 0.0005 | 0.0003 | 0.0013 | 0.0001 | 0.0007 | 0.0003 | 0.0001 | 0.0005 |
| Bud Periphery | 0.0004 | 0 | 0.0003 | 0.0012 | 0.002 | 0.0003 | 0.0005 | 0 | 0.0002 | 0.0002 | 0.0001 | 0.0001 | 0.0008 | 0 | 0.0006 | 0.0001 | 0 | 0 |
| Bud Site | 0.0014 | 0 | 0.0005 | 0.0023 | 0.0022 | 0.0001 | 0.0036 | 0.0001 | 0.0001 | 0.0002 | 0.0001 | 0 | 0.0006 | 0.0001 | 0.0004 | 0.0002 | 0 | 0 |
| Cell Periphery | 0.0003 | 0 | 0.0001 | 0.0003 | 0.0001 | 0.0001 | 0.0004 | 0 | 0.0001 | 0.0002 | 0 | 0 | 0.0005 | 0 | 0.0001 | 0 | 0 | 0 |
| Cytoplasm | 0.0079 | 0.0001 | 0.0004 | 0.0195 | 0.004 | 0.0003 | 0.0014 | 0.0007 | 0.0016 | 0.001 | 0.0014 | 0.0002 | 0.0012 | 0.0024 | 0.0013 | 0.0029 | 0.0001 | 0 |
| Cytoplasmic Foci | 0.004 | 0 | 0.0073 | 0.0039 | 0.0021 | 0.0002 | 0.0047 | 0.0002 | 0.0005 | 0.0007 | 0.0038 | 0.0001 | 0.0117 | 0 | 0 | 0.0064 | 0 | 0 |
| Eisosomes | 0 | 0 | 0 | 0.0001 | 0.0003 | 0 | 0.0001 | 0 | 0 | 0 | 0 | 0 | 0.0001 | 0 | 0 | 0 | 0 | 0 |
| Endoplasmic Reticulum | 0.0041 | 0 | 0.0003 | 0.002 | 0.0007 | 0.0003 | 0.0015 | 0.0001 | 0.0011 | 0.0009 | 0.0004 | 0.0002 | 0.0024 | 0.0002 | 0.0002 | 0.0011 | 0 | 0 |
| Endosome | 0.0163 | 0 | 0.0069 | 0.0074 | 0.0026 | 0.0009 | 0.0066 | 0.0002 | 0.002 | 0.0169 | 0.0146 | 0.0012 | 0.0051 | 0 | 0.0001 | 0.0176 | 0 | 0 |
| Golgi | 0.0015 | 0 | 0.0024 | 0.0044 | 0.0025 | 0.0001 | 0.0013 | 0 | 0.0002 | 0.001 | 0.0009 | 0.0003 | 0.0014 | 0 | 0 | 0.0019 | 0 | 0 |
| Lipid Particles | 0.0168 | 0 | 0.0073 | 0.0062 | 0.0139 | 0.0009 | 0.0074 | 0.0002 | 0.0002 | 0.0037 | 0.0041 | 0.001 | 0.0059 | 0 | 0 | 0.0088 | 0 | 0 |
| Mitochondria | 0.0017 | 0.0001 | 0.0046 | 0.0031 | 0.0034 | 0.0005 | 0.0016 | 0.0002 | 0.0012 | 0.0013 | 0.0003 | 0.0005 | 0.0091 | 0.0001 | 0.0006 | 0.0006 | 0.0005 | 0.0001 |
| None | 0.0025 | 0 | 0.0003 | 0.0304 | 0.042 | 0.0006 | 0.0011 | 0.0067 | 0.0008 | 0.0009 | 0.0119 | 0.001 | 0.001 | 0.0001 | 0.0001 | 0.0219 | 0 | 0 |
| Nuclear Periphery | 0.0105 | 0.0015 | 0.0172 | 0.0038 | 0.0255 | 0.0089 | 0.0114 | 0.0049 | 0.0044 | 0.0059 | 0.0043 | 0.0026 | 0.005 | 0.0025 | 0.0025 | 0.0204 | 0.0012 | 0.0004 |
| Nucleolus | 0.0172 | 0.0143 | 0.0122 | 0.0098 | 0.0353 | 0.0354 | 0.014 | 0.0131 | 0.0123 | 0.0159 | 0.0359 | 0.0276 | 0.0155 | 0.0122 | 0.0251 | 0.0084 | 0.0781 | 0.035 |
| Nucleus | 0.8874 | 0.9758 | 0.9175 | 0.8764 | 0.7957 | 0.944 | 0.9181 | 0.9584 | 0.9676 | 0.9419 | 0.8994 | 0.9576 | 0.9017 | 0.9714 | 0.9629 | 0.8851 | 0.9148 | 0.9522 |
| Peroxisomes | 0.0019 | 0 | 0.0086 | 0.002 | 0.0089 | 0 | 0.0017 | 0 | 0.0001 | 0.0002 | 0.0004 | 0.0001 | 0.0097 | 0 | 0 | 0.0011 | 0 | 0 |
| Punctate Nuclear | 0.0126 | 0.008 | 0.007 | 0.0144 | 0.036 | 0.0043 | 0.0114 | 0.0145 | 0.005 | 0.004 | 0.0206 | 0.0058 | 0.0043 | 0.0107 | 0.0035 | 0.0187 | 0.0049 | 0.0115 |
| Vacuole | 0.0075 | 0 | 0.0033 | 0.004 | 0.0008 | 0.0011 | 0.0016 | 0.0004 | 0.0007 | 0.0032 | 0.0007 | 0.0001 | 0.0025 | 0.0002 | 0.0009 | 0.0012 | 0.0001 | 0.0001 |
| Vacuole Periphery | 0.0014 | 0 | 0.002 | 0.0008 | 0.0011 | 0.0004 | 0.0012 | 0.0002 | 0.0007 | 0.0015 | 0.0003 | 0.0002 | 0.0016 | 0 | 0.0004 | 0.0007 | 0.0001 | 0.0001 |
Sequencing Data
| R1 | R2 | |||||||||
|---|---|---|---|---|---|---|---|---|---|---|
| G1 Post-START | S/G2 | Metaphase | Anaphase | Telophase | G1 Post-START | S/G2 | Metaphase | Anaphase | Telophase | |
| Gene Expression | 32.3529 | 19.281 | 20.3315 | 25.5987 | 21.3414 | 26.0949 | 19.2385 | 18.0054 | 20.2433 | 31.2022 |
| Translational Efficiency | 1.5519 | 1.4607 | 1.2974 | 1.1349 | 1.8092 | 2.1695 | 1.6336 | 1.3949 | 1.6914 | 1.4875 |
Hit Data
| Dataset | Hit |
|---|---|
| Protein Concentration | ✔ |
| Protein Localization | ✘ |
| Gene Expression | ✘ |
| Translational Efficiency | ✘ |
Endocytosis
| Temp | Actin Patch (Sac6-tdTomato) | Cortical Patch (Sla1-GFP) | Late Endosome (Snf7-GFP) | Vacuole (Vph1-GFP) |
|---|---|---|---|---|
| 37℃ | ||||
| RT |
Cell Cycle Omics
CYCLoPs (Rfc4-GFP)
| Gene / Allele | Actin Patch (Sac6-tdTomato) | Cortical Patch (Sla1-GFP) | Late Endosome (Snf7-GFP) | Vacuole (Sac6-tdTomato) |
|---|
| Gene | Images |
|---|
| Gene | Images |
|---|
Images are not yet available
Images are not yet available